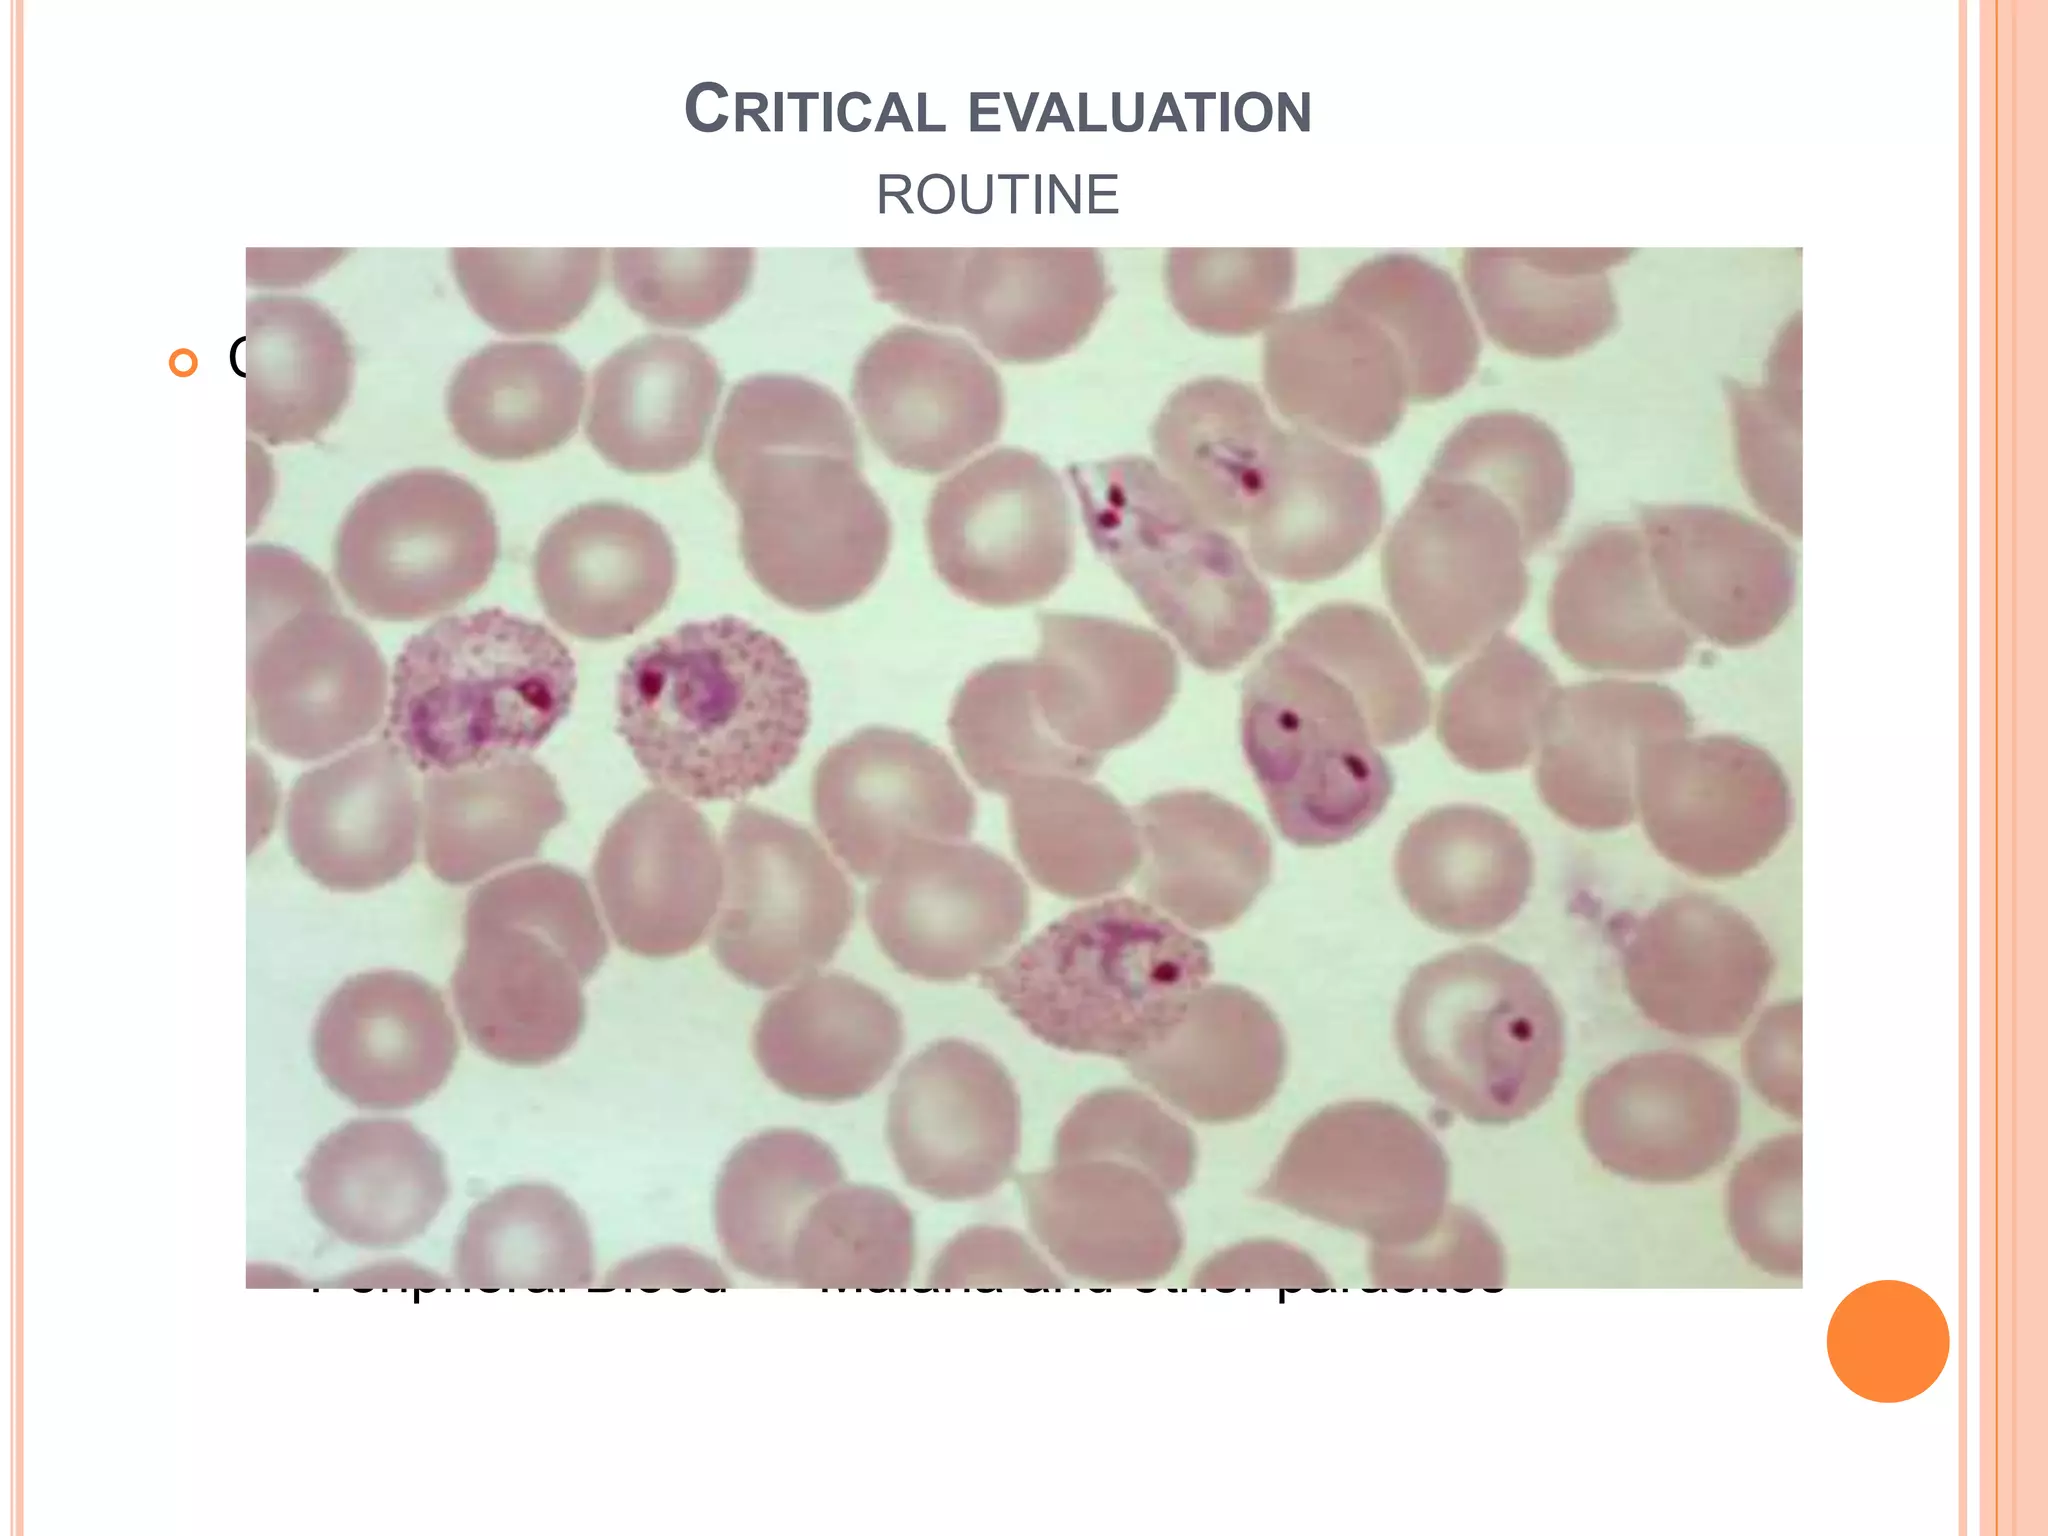
 Complete Blood Count
 Anemia suggests a serious underlying disease
 Leukocytosis with bands → occult bacterial infection
 Lymphocytosis & atypical lymphocyte → Infectious
mononucleosis
 Leucopenia and lymphopenia → advanced HIV, typhoid
 Leukoerythroblastic Anemia → Disseminated TB
 Thrombocytopenia → Malaria/Leukemia
 Peripheral Blood → Malaria and other parasites
CRITICAL EVALUATION
ROUTINE

This document discusses pyrexia of unknown origin (PUO). It begins by defining PUO according to old and new definitions. It then expands the new definition to include categories like nosocomial PUO, neutropenic PUO, and HIV-associated PUO. The document goes on to discuss the causes of PUO in different regions and time periods, with infectious diseases like tuberculosis being very common. It also outlines the evaluation and diagnostic approach for PUO, including relevant laboratory tests, physical exam findings, and potential etiologies.